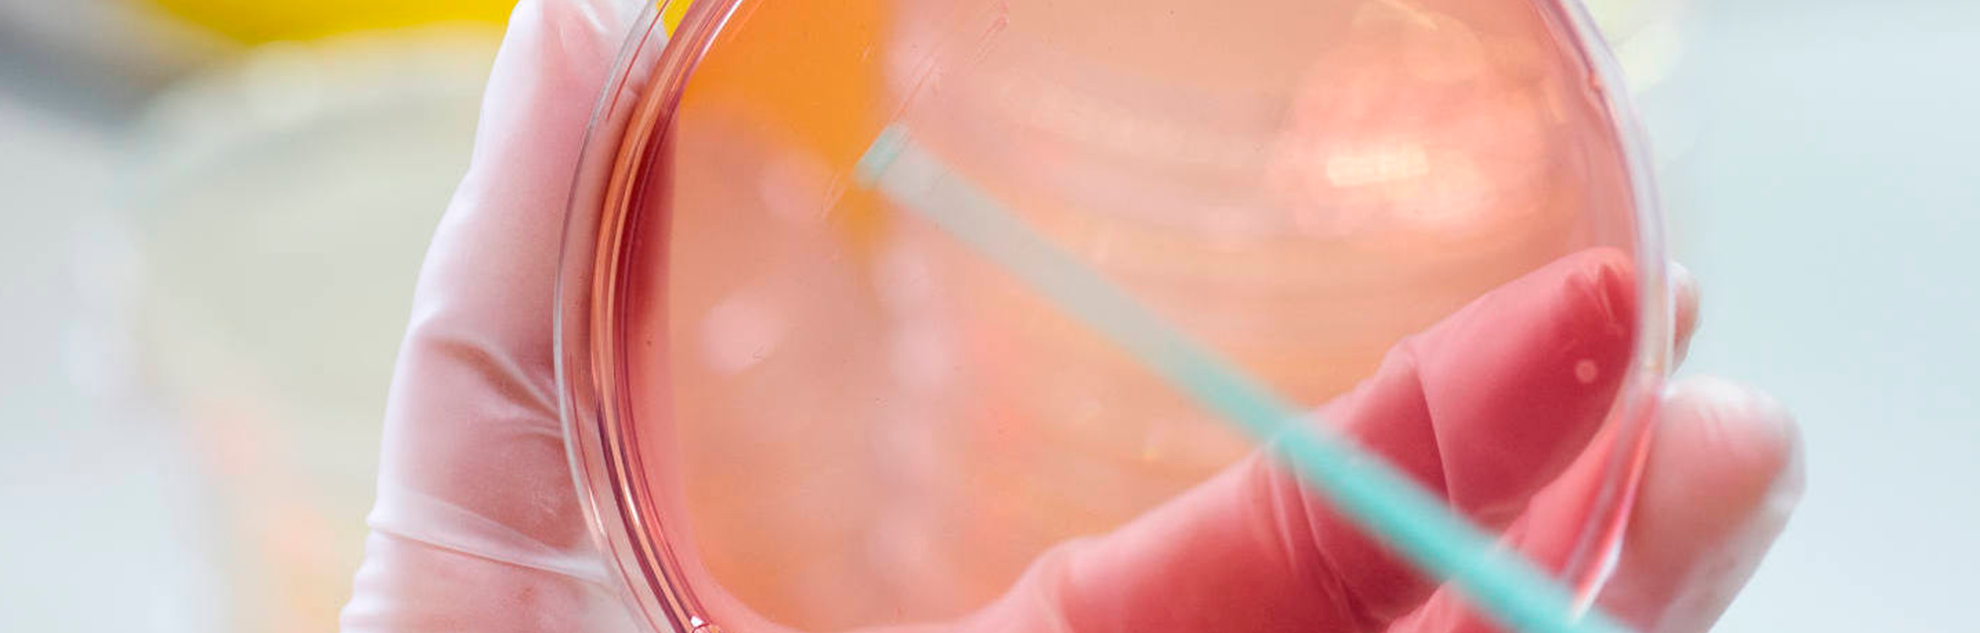

Resistències Antimicrobianes
Contribuïm al coneixement de les causes i factors de risc de les resistències antimicrobianes, així com al desenvolupament de nous medicaments

La resistència a fàrmacs antimicrobians posa en risc els avanços aconseguits en salut global en les últimes dècades.
La resistència a fàrmacs antimicrobians és un repte important de salut global i amenaça la nostra capacitat de tractar malalties infeccioses. La resistència a medicaments de primera línia suposa a més una càrrega econòmica considerable, ja que allarga la durada de la malaltia (mes dies d'hospitalització) i del tractament, i resulta en la utilització de teràpies més cares.
La resistència antimicrobiana és un procés natural pel qual microorganismes (bacteris, virus, paràsits o altres patògens) desenvolupen resistències als fàrmacs que s'utilitzen per tractar-los. L'abús i el mal ús dels antibiòtics i altres fàrmacs antimicrobians afavoreix el desenvolupament i propagació de microorganismes resistents, i genera una major necessitat d'administrar tractaments alternatius eficaços. Malgrat això, en les últimes dècades hi ha hagut un descens continu en el nombre de medicaments aprovats. En els últims 30 anys solament s'han aprovat tres antibiòtics nous.

L'efectivitat dels antibiòtics actuals es veu cada cop més amenaçada per la resistència als fàrmacs antimicrobians. Tot i així, en els últims 30 anys només s'han aprovat tres antibiòtics nous
Jordi Vila, Director de la iniciativa de Resistències Antimicrobianes
La resistència antimicrobiana també afecta altres malalties no bacterianes. La resistència del paràsit de la malària als antimalárics cloroquina i sulfadoxina-pirimetamina está generalitzada en la majoria dels països amb malària endèmica; a més, en el sud-est d'Àsia estan sorgint paràsits P. falciparum resistents a la artemisinina. En el tractament de la infecció per VIH, la resistència és una preocupació cada vegada major arran de la ràpida expansió en l'accés als medicaments antirretrovirals en els últims anys.
Dades clau
Per lluitar contra els patògens resistents, es requereix responsabilitat i participació de tota la societat. Alguns dels factors clau són:
- el reforç dels sistemes de seguiment i vigilància de la resistència als antibiòtics
- l'accés a medicaments essencials i de qualitat, així com promoure un ús racional dels mateixos, inclòs en l'àmbit veterinari
- millorar la prevenció i control d'infeccions
- fomentar la innovació, recerca i desenvolupament de noves eines (antibiòtics, bovines…)
La Iniciativa de Resistència Antimicrobiana d’ISGlobal està pensada per contribuir a la lluita contra l'emergència i propagació de patògens resistents a fàrmacs antimicrobians des d'un enfocament multidisciplinari a través de les activitats centrals d’ISGlobal: recerca, formació, anàlisi i assistència tècnica.
Projecte destacat de la iniciativa:
Aliança Internacional per combatre la Resistència als antibiòtics: El projecte finançat per la Wellcome-Trust busca establir una xarxa interdisciplinària per enfortir la recerca en resistència antimicrobiana que creua ciències biomèdiques, socials i barreres geogràfiques. El projecte, coordinat pel Centre de Salut Global de la Universitat de Sussex, inclou a l'Institut de Salut Global de Barcelona (ISGlobal) i l'Institut de Microbiología, Inmunologia i Higiene de la Universitat de Colònia (IMMH).
Recursos
- Els superbacteris a la ciutat (article web)
- Què hem de tenir en compte a l'hora de prendre antibiòtics? (article web)
Our Team
Director de la iniciativa
-
Jordi Vila Estapé Research Professor i director de la Iniciativa de Resistències Antimicrobianes
Coordinadora de la iniciativa
-
Elisabet Guiral Gestora de programes i projectes, i Coordinadora de la Iniciativa de Resistències Antimicrobianes
El nostre equip
-
Victoria Ballen Torres
-
Marta Marí Predoctoral Fellow -
Laura Muñoz Tècnic de Suport Científic - Laboratori -
Ignasi Roca Associated Researcher -
Sara Soto González Associate Research Professor i directora del Programa d'Infeccions Víriques i Bacterianes -
Marina Tarrús Tècnica de divulgació científica de la iniciativa RAM

